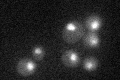
YPL122C
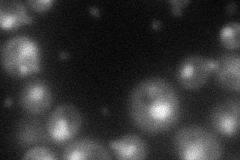
YPL122C
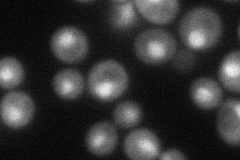
YPL122C
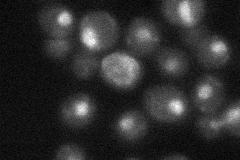
YPL122C
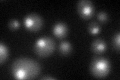
YPL122C
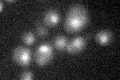
YPL122C
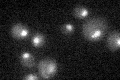
YPL122C

View description
Subunit of TFIIH and nucleotide excision repair factor 3 complexes, involved in transcription initiation, required for nucleotide excision repair, similar to 52 kDa subunit of human TFIIH
Localization:
Intensity:
Fold change:
Significance:
-
C’ GFP library in SD
nucleus24.71 -
N' NOP1pr-GFP in SD
nucleus63.1504 -
N' TEF2pr-mCherry in SD
nucleus54.6801 -
N' NATIVEpr-GFP in SD
nucleus29.6627 -
N' TEF2pr-VC and Cyto-VN in SD

cytosol29.6178 -
C’ GFP library in SD+DTT
nucleus31.821.28No -
C’ GFP library in SD+H2O2
nucleus26.481.07No -
C’ GFP library in Starvation Media
nucleus18.810.76Yes -
C’ GFP library on the background of Pup2-DaMP

nucleus -
C’ GFP library on the background of CCT mutant

nucleus31.32151.26743No
